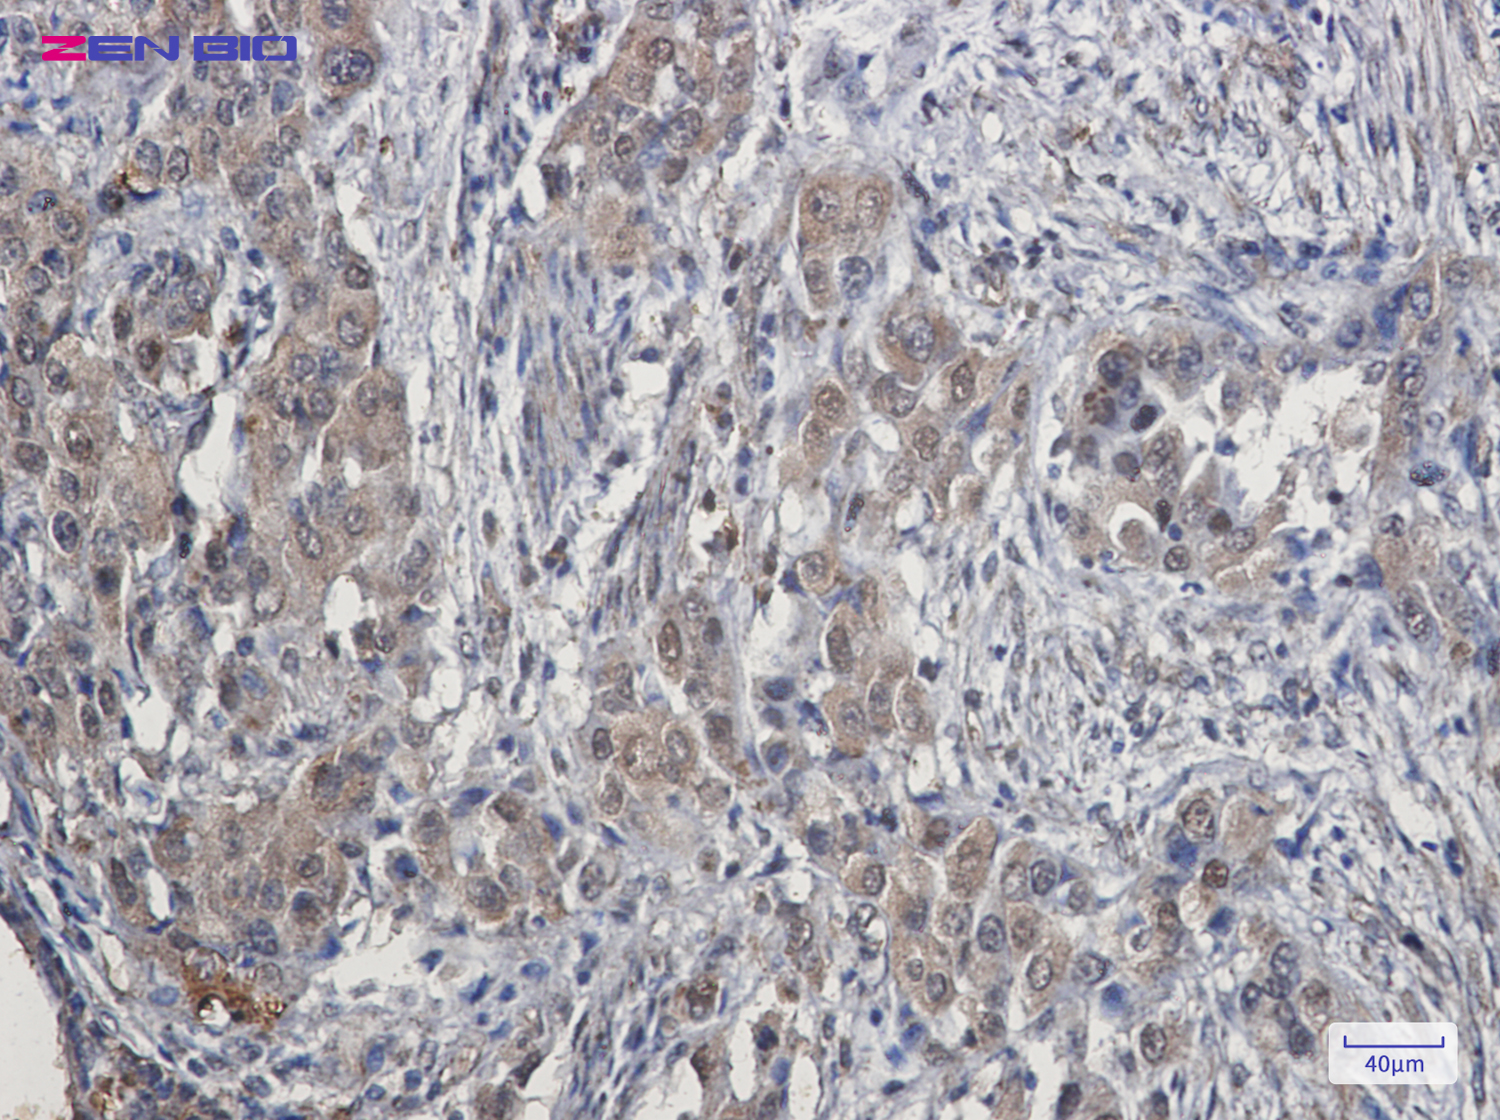

-
Product Name
Anti-Cdk4 Rabbit antibody
- Documents
-
Description
Cdk4 Rabbit polyclonal antibody
-
Tested applications
WB, IHC-P, ICC/IF, IP
-
Species reactivity
Human, Mouse, Rat
-
Alternative names
CMM3; PSK-J3 antibody
-
Isotype
Rabbit IgG
-
Preparation
Antigen: Recombinant protein of human Cdk4
-
Clonality
Polyclonal
-
Formulation
Supplied in 50nM Tris-Glycine(pH 7.4), 0.15M Nacl, 40%Glycerol, 0.01% sodium azide and 0.05% BSA.
-
Storage instructions
Store at -20°C. Stable for 12 months from date of receipt.
-
Applications
WB: 1/1000
IHC: 1/50
ICC/IF: 1/50
IP: 1/20
-
Validations

Western blot detection of Cdk4 in K562,C6,3T3,Hela cell lysates using Cdk4 Rabbit pAb(1:1000 diluted).Predicted band size:34kDa.Observed band size:34kDa.
Immunohistochemistry of Cdk4 in paraffin-embedded Human lung cancer tissue using Cdk4 Rabbit pAb at dilution 1/50
-
Background
Swiss-Prot Acc.P11802.Ser/Thr-kinase component of cyclin D-CDK4 (DC) complexes that phosphorylate and inhibit members of the retinoblastoma (RB) protein family including RB1 and regulate the cell-cycle during G1/S transition. Phosphorylation of RB1 allows dissociation of the transcription factor E2F from the RB/E2F complexes and the subsequent transcription of E2F target genes which are responsible for the progression through the G1 phase. Hypophosphorylates RB1 in early G1 phase. Cyclin D-CDK4 complexes are major integrators of various mitogenenic and antimitogenic signals. Also phosphorylates SMAD3 in a cell-cycle-dependent manner and represses its transcriptional activity. Component of the ternary complex, cyclin D/CDK4/CDKN1B, required for nuclear translocation and activity of the cyclin D-CDK4 complex.
Related Products / Services
Please note: All products are "FOR RESEARCH USE ONLY AND ARE NOT INTENDED FOR DIAGNOSTIC OR THERAPEUTIC USE"
